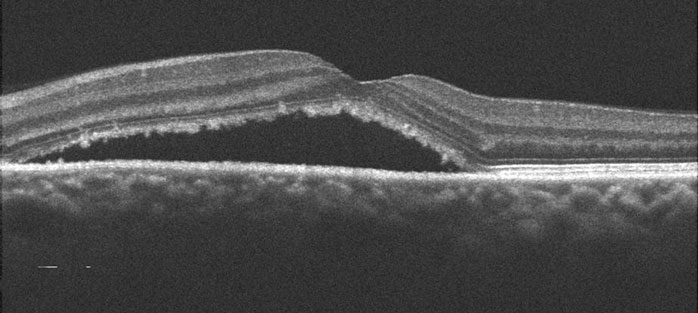

Central serous retinopathy (CSR) is an eye disorder characterized by a blister of fluid beneath the macula, the small, specialized area of the retina that gives us our straight-ahead reading and driving vision. CSR generally affects younger men but is becoming increasingly prevalent in women as well.
The majority of blisters will resolve spontaneously within 3 to 4 months with return of essentially normal vision. In some cases, however, CSR does not get better or has more severe symptoms that may require treatment. Though this disease may clear up on its own, it is important that any sudden changes in your vision be thoroughly examined by a qualified eye doctor. Bennett & Bloom Eye Centers is committed to your eye health. We stay at the forefront of technology and currently offer a number of treatment options for this disease.

The hallmark clinical finding of CSR consists of one or more “blisters” of fluid (serous detachment) beneath the macula. The vast majority of blisters will resolve spontaneously within 3 to 4 months. Vision usually returns to normal, although many patients are left with subtle changes in their central or color vision. Patients will often develop recurrent leaks in one or both eyes over the years.


CSR has historically been found in young to middle-aged men although it is becoming increasingly common in women as well. Type A personality (competitive drive, sense of urgency, and aggressive nature) may be a risk factor for its development. It can also be caused by corticosteroid pills or injections

You can’t diagnose CSR by looking in the mirror since your eye will usually look and feel normal. The diagnosis is made with a thorough retinal examination through a dilated pupil, along with OCT scanning and fluorescein angiography. Angiography is helpful in confirming the diagnosis, as well as in identifying the leak when contemplating treatment.


Treatment for most patients with CSR is usually not necessary since most cases resolve spontaneously within 3 to 4 months. Early treatment should be considered, however, for those people whose distortion, vision loss, and difficulty with depth perception make their daily activities such as reading and driving difficult. Treatment is also considered if visual symptoms remain for persistent central blisters.
A laser is an instrument that produces a pure, high-intensity beam of light energy. The laser light can be focused onto the retina, selectively treating the desired area while leaving the surrounding tissues untouched. The absorbed energy heats, or photocoagulates, the retina, creating a microscopic spot. Laser surgery is performed in our office while you are awake and comfortable. The laser treatment usually takes several minutes to complete and you can go home immediately following surgery. Arrangements for transportation should be made in advance since you may not be able to drive right away. Photocoagulation decreases the duration of CSR by several months, although it appears to have little effect on the final vision or recurrence rate.


Photodynamic therapy, traditionally used for treating macular bleeding (macular neovascularization) in wet age-related macular degeneration and ocular histoplasmosis, has emerged as the treatment of choice for most eyes with CSR. The outpatient procedure is painless and performed in our office. A special photodynamic dye is injected into an arm vein. Fifteen minutes later, a “cold” laser light is aimed at area of subretinal leakage. The laser light activates the dye, causing the production of a very active form of oxygen (singlet oxygen) that seals the leak. Patients can go home immediately following photodynamic therapy but must avoid direct sunlight for 2 days following treatment to avoid skin burns from the dye.